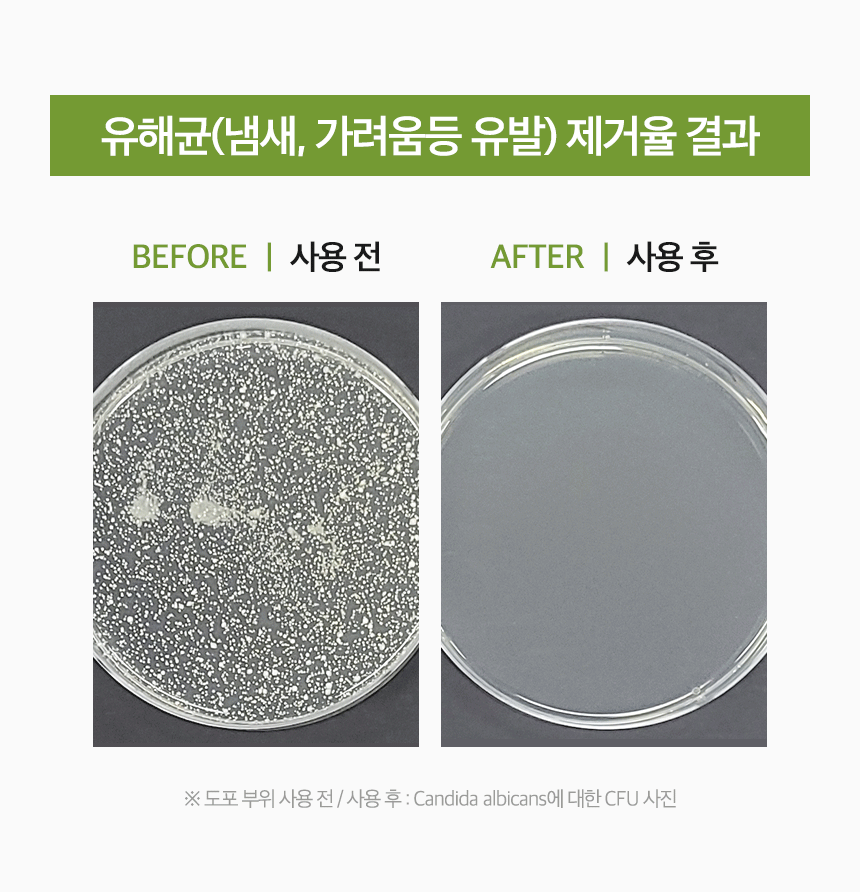
이븐로엘_녹두캐릭터_15.gif

今日の為替レート
お振込銀行
クレジットカード支払い
ログイン | LOGIN
商品カテゴリー
- ブランドファッション
- ファッション/雑貨
- ビューティー
- 食品
- 出産/育児
- 生活雑貨
- パソコン
- レジャー
(주문폭주) 온가족 청결제 항문세정제 여성 남성 Y존 클렌저
|
|||||||||||||||||
| 商品購入についてのご案内 | |||
|
|||



































|
|||||||||||||||||
| 商品購入についてのご案内 | |||
|
|||